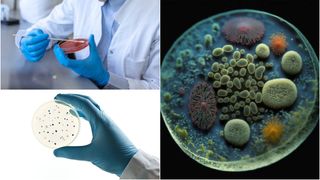
bacterie in laborator
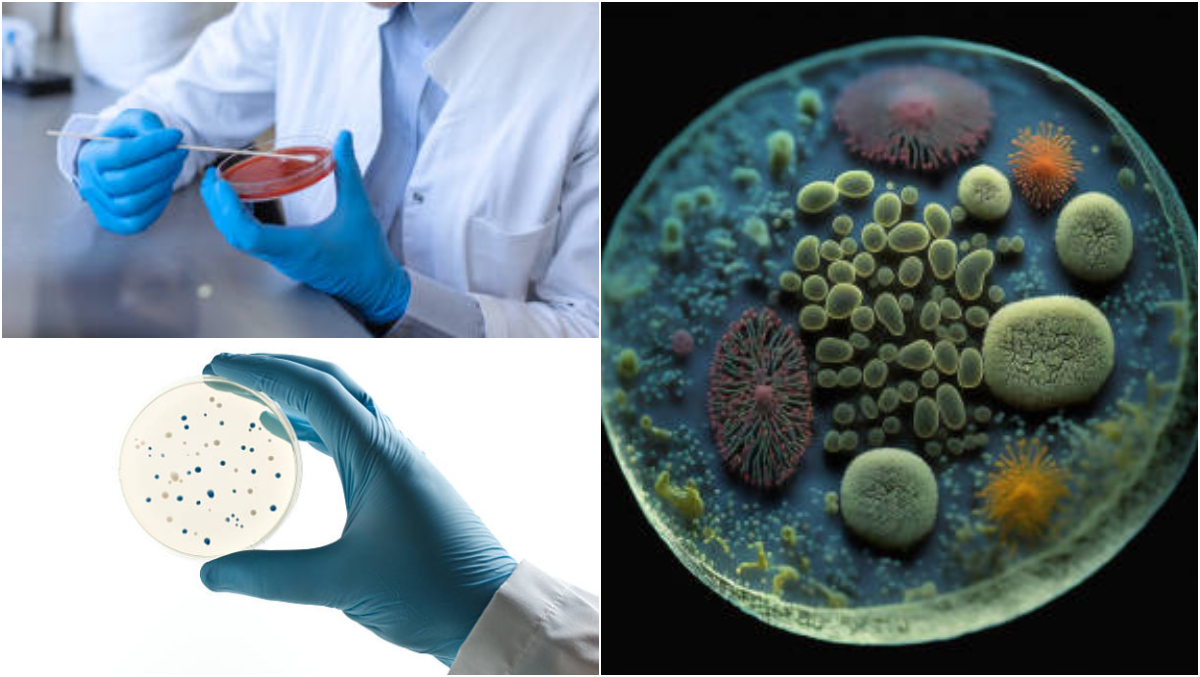

1 din 4 | O nouă boală mortală înspăimântă omenirea! Primele cazuri au fost deja raportate. Unde s-au depistat?
2 din 4 | O nouă boală bacteriană mortală înspăimântă omenirea
3 din 4 | Primele cazuri au fost deja raportate în Japonia
4 din 4 | O nouă boală bacteriană mortală înspăimântă omenirea! Primele cazuri au fost deja raportate în Japonia
În Japonia a apărut o nouă boală bacteriană, cu o rată ridicată a mortalității. Oamenii sunt înspăimântați și se tem de ce e mai rău, mai ales că primele simptome sunt caracteristice unei răceli banale.
O nouă boală bacteriană, cu rata mortalității ridicată, și-a făcut apariția în Japonia. Primele cazuri au fost deja confirmate, iar oamenii se tem de ce e mai rău.
Simptomatologia bolii este înspăimântătoare, deoarece, la început, se manifestă precum o răceala banală.
Boala bacteriană mortală. Primele cazuri confirmate în Japonia
Specialiștii au declarat că Japonia este lovită de o nouă boală bacteriană.
Boala bacteriană ale căror prime cazuri au fost deja confirmate a înspăimântat populația. Cu atât mai mult, specialiștii au declarat că rata mortalității provocate de această bacterie ajunge la 30%, relatează theguardian.com.
Bacteria care a provocat alertă în Japonia este sindromul de șoc toxic streptococic.
Există încă mulți factori necunoscuți cu privire la mecanismele din spatele formelor fulminante (severe și bruște) de streptococ și nu suntem în stadiul în care să le putem explica, au declarat specialiștii din cadrul Institutului Național de Boli Infecțioase din Japonia, potrivit theguardian.com.
Experții din cadrul Institutului Național de Boli Infecțioase din Japonia au raportat că în anul 2023 au fost înregistrate 941 de cazuri de sindrom de șoc toxic streptococic. De la începutul anului 2024, au fost raportate 378 de cazuri.
Persoanele cu vârsta de peste 50 de ani prezintă un risc mai mare de a muri din cauza aceste bacterii. Totuși, specialiștii sunt îngroziți că cele mai multe decese provocate de sindromul de șoc toxic streptococic au fost raportate în cazul persoanelor tinere, cu vârste de până în 45 de ani.
Sindromul de șoc toxic streptococic își face apariția prezentând semne ușoare de răceala, precum tuse sau durere în gât.